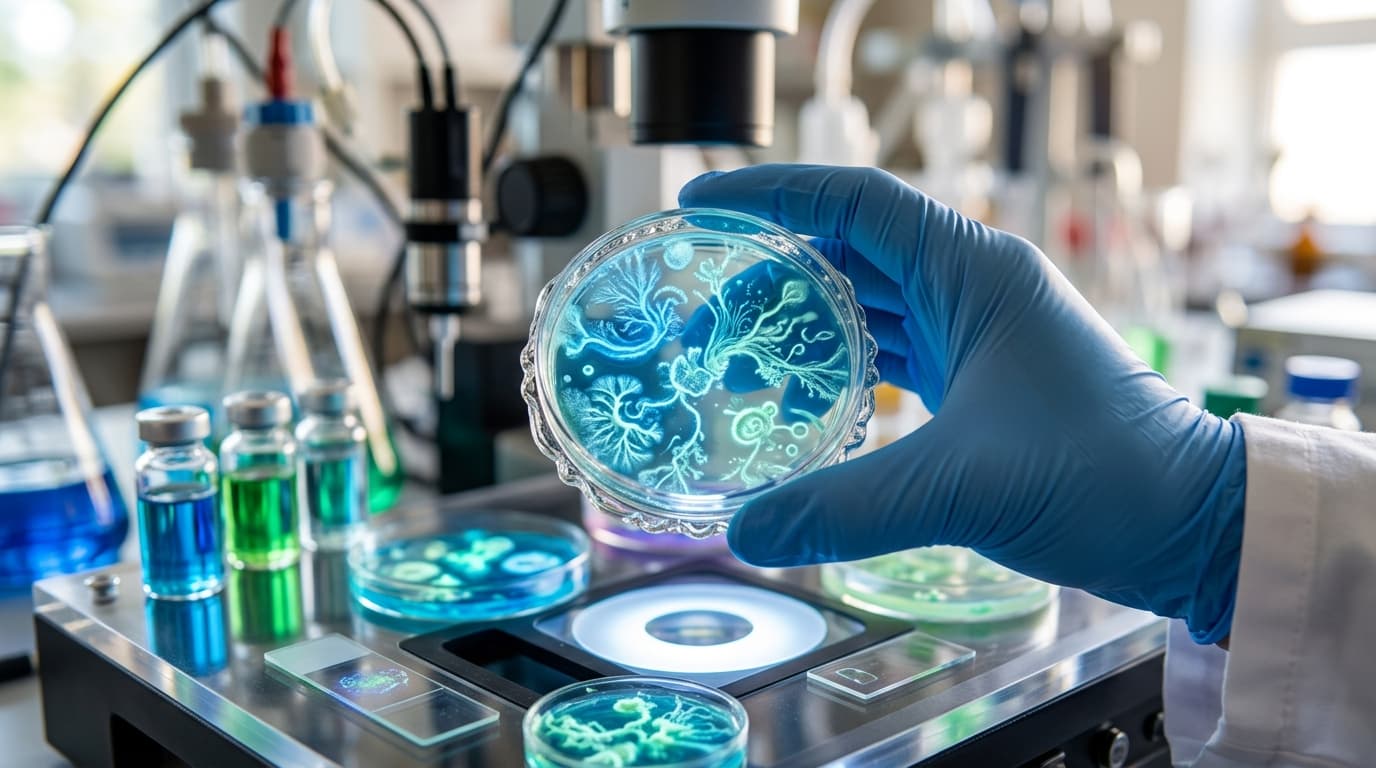
Andy Weir on Project Hail Mary Movie & Ryan Gosling

Sports
How Arizona and Illinois Won Elite Eight for Final Four
The Wildcats and Fighting Illini punched their tickets to Indianapolis with dominant Elite Eight performances. Arizona's defense stifled Purdue while Illinois overwhelmed Iowa.
Your trusted source for timely, AI-powered insights
Tottenham Hotspur have dismissed Igor Tudor following a devastating five-game winless run that plunged the club into an unprecedented relegation battle in the Premier League.

Mike Johnson

Laboratory gloves may contaminate microplastics research, inflating environmental pollution estimates. Scientists are developing new protocols to address this critical measurement error.

Alex Chen

Canadian astronaut Jeremy Hansen will become the first person from his country to fly around the moon on NASA's Artemis 2 mission, marking a historic milestone for Canada's space program.

James Wilson


Sports
The Wildcats and Fighting Illini punched their tickets to Indianapolis with dominant Elite Eight performances. Arizona's defense stifled Purdue while Illinois overwhelmed Iowa.

Business
Aluminium Bahrain confirms Iranian drone attack on world's largest aluminum smelter, creating supply uncertainty and raising strategic concerns for global manufacturers and investors.

Science
Author Andy Weir reveals his excitement about Ryan Gosling's performance in the Project Hail Mary film, praising how the actor adds emotional layers to the beloved character.

Sports
The Wildcats and Fighting Illini punched their tickets to Indianapolis with dominant Elite Eight performances. Arizona's defense stifled Purdue while Illinois overwhelmed Iowa.

Business
Aluminium Bahrain confirms Iranian drone attack on world's largest aluminum smelter, creating supply uncertainty and raising strategic concerns for global manufacturers and investors.
Science
Author Andy Weir reveals his excitement about Ryan Gosling's performance in the Project Hail Mary film, praising how the actor adds emotional layers to the beloved character.

Entertainment
Martin Short was spotted in his first public outing since the tragic death of his daughter Katherine, prompting an outpouring of support from Hollywood and fans worldwide.

Sports
The No. 1 seed Arizona Wildcats ended a 24-year drought, defeating Purdue 76-64 to reach their first Final Four since 2001. A dominant performance showcased championship potential.

Technology
Apple quietly tests revolutionary privacy capabilities that go beyond current protections. These enhancements could set new industry standards for user data security and control.
Entertainment
New York City has served as the backdrop for countless unforgettable moments in film and television. These 47 iconic locations let you walk in your favorite characters' footsteps.

Technology
GitLab's co-founder Sid Sijbrandij faces terminal cancer with an unconventional strategy: building new companies. His approach redefines resilience in tech leadership.

Technology
Discover how to customize your Kontakt sampler with unique wallpapers. Get tips on requesting designs, installation, and creating the perfect production environment.
Discover the latest content across our most popular categories

Spain transformed its legal system by hosting legislation on GitHub. This groundbreaking approach uses version control to track every change, making lawmaking transparent and accessible.

Applied compression theory demystified for music producers. Learn how to control dynamics, choose the right settings, and avoid common mistakes that ruin your mixes.

LG's breakthrough 1Hz display technology dynamically adjusts screen refresh rates to extend laptop battery life by 3-5 hours, revolutionizing mobile productivity for professionals and students.

Yemen's Houthis launched their first strike on Israel, escalating the conflict into its second month. This analysis examines critical business implications for global markets.

Wall Street's bonus pool hit a record $49.2 billion in 2025. Learn how much bankers made, what drove the increase, and key implications for business leaders and entrepreneurs.

Learn how successful solopreneurs use seven essential AI tools to automate operations, create content, and build six-figure one-person businesses without hiring employees.

Disneyland Paris transforms Disney Adventure World with the spectacular World of Frozen, featuring Arendelle's ice palace, thrilling attractions, and character encounters.

Reality TV mogul Kylie Jenner has listed her longtime Hidden Hills mansion for $20.3 million, marking a significant real estate move as her relationship with Timothée Chalamet continues.

Ye's Los Angeles shows at SoFi Stadium are selling out fast. Discover where to find legitimate last-minute tickets online and secure your spot at one of 2024's biggest concerts.

GitHub now uses Copilot Free, Pro, and Pro+ interaction data for AI training starting April 24. Discover what changed, how it affects your code, and steps to opt out.

After months of hype, 2025 was supposed to revolutionize coding with AI agents. Here's what actually happened and what developers should know about working with AI tools today.

Han breaks language barriers in programming by offering Korean syntax powered by Rust. Discover how this innovative language makes coding more accessible for Korean-speaking developers.

Technology
Apple has officially confirmed the end of the Mac Pro line, marking a significant shift in its professional computing strategy. Here's what pro users need to know about this decision.

Technology
Instagram's audio processing transforms your music through compression and mobile optimization. Learn why tracks sound punchier on the platform and how to mix accordingly.

Entertainment
Acclaimed Japanese filmmaker Shinya Tsukamoto brings his war trilogy to a powerful conclusion with 'Mr. Nelson, Did You Kill People?' a haunting Vietnam veteran drama hitting Japanese theaters.

Sports
A landmark LA verdict found Meta and YouTube negligent for social media addiction. For young athletes navigating digital platforms, this decision changes everything about screen time and wellbeing.

Lifestyle

Technology

Technology
Apple has officially confirmed the end of the Mac Pro line, marking a significant shift in its professional computing strategy. Here's what pro users need to know about this decision.

Technology
Instagram's audio processing transforms your music through compression and mobile optimization. Learn why tracks sound punchier on the platform and how to mix accordingly.

Entertainment
Acclaimed Japanese filmmaker Shinya Tsukamoto brings his war trilogy to a powerful conclusion with 'Mr. Nelson, Did You Kill People?' a haunting Vietnam veteran drama hitting Japanese theaters.

Sports
A landmark LA verdict found Meta and YouTube negligent for social media addiction. For young athletes navigating digital platforms, this decision changes everything about screen time and wellbeing.

Lifestyle
Scientists have identified the single most powerful emotional trigger behind addictive behavior. Understanding this connection could transform how we approach recovery and prevention.

Technology
A deep dive into the White House's official mobile application reveals fascinating technical choices, security implementations, and design decisions that reflect modern government tech.
Get the latest trending topics and AI-powered insights delivered to your inbox.